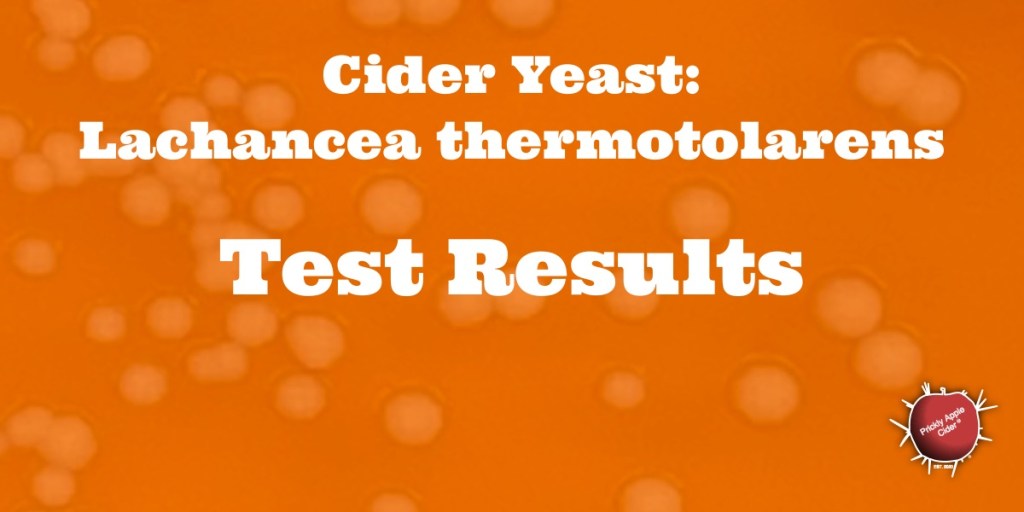
Non-Saccharomyces Yeast:  Lachancea thermotolarens&nbsp;Results

While Saccharomyces Cerevisiae is the dominant yeast use for beer and wine, is it the best yeast for making hard cider? Many Saccharomyces Cerevisiae strains used for beer have mutated through yeast harvesting, cropping, and selective pressure placed on them over many years. These have created yeast strains that leave more or less residual sugar or generate flavors associated with the various beer style. The Saccharomyces Cerevisiae strains used in wine are less evolved because they are usually not reused. However, they are often selected to handled high sugar content while creating high aromas compounds. Hard cider is low alcohol, 4-8% ABV, like beer, but doesn’t contain the complex malt sugars found in beer. This means the attenuation identified for beers, doesn’t hold for hard cider. We are again faced with the issue that hard cider is neither beer or wine. However, we often continue to try to apply concepts like yeast and nutrient additions from wine for our hard cider.
I have some theories that good hard cider should not need nutrients and it should be able to have lower attenuation when desired. I believe the problems found in the hard cider making process due to aroma, acid, sweetness, and phenols are more associated with the apples and the yeast than anything else. What J. Wei and his associates (1) showed in their research is that non-Saccharomyces yeast strains can be used for hard cider and these yeasts can create aromas that exceed Saccharomyces Cerevisiae. These yeasts can also leave more residual sweetness. What they are finding gives me hope that there are genera of yeast that are ideal for making hard cider. These won’t require nutrients and can even create hard ciders with natural residual sweetness. In the above table, I have highlighted five examples of non-Saccharomyces yeast strains they found generate aromas at levels above those of Saccharomyces Cerevisiae. It’s a great example of how little we know about the yeast that we should be using for hard cider production. However, it does gives us a peek at the potential.
(1) J. Wei and associates, Characterization and screening of non-Saccharomyces yeasts used to produce fragrant cider, LWT – Food Science and Technology 107 (2019) 191–198
Don’t miss any future Mālus Trivium articles. Follow me and you will get a link to my latest article delivered to your inbox. It’s that easy!